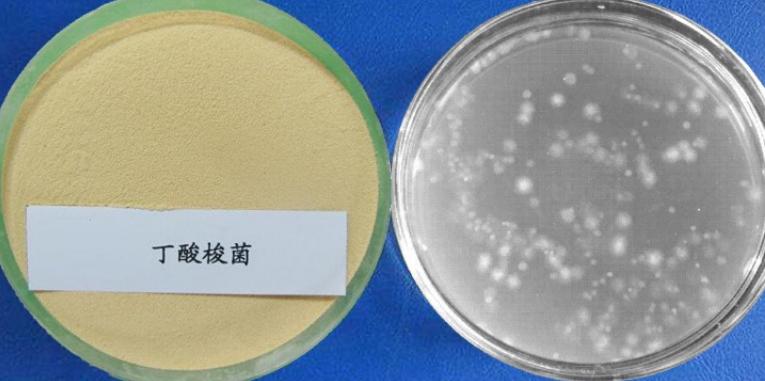

1.Product Features:
The strain has the characteristics of high temperature resistance, strong stress resistance and strong butyric acid production.Medium supplemental amount: 20-50g for piglets and sows; The additive amount of fattening pigs was 30g. Add 30-50g of poultry feed; skin Add 30g for hairy animals.



Ms Wendy Lee
Mobile&Wechat&Whatsapp : 0086 13562692198
Email :yuedongbiotech@aliyun.com
Ms Jeff Wang
Mobile&Wechat&Whatsapp : 0086 13563622867
Email :wfyuedong@aliyun.com
Ms Sundy Lee
Mobile&Wechat&Whatsapp : 0086 15965090376
Email :yuedongsundy@aliyun.com


